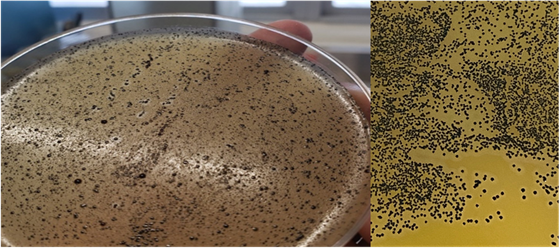
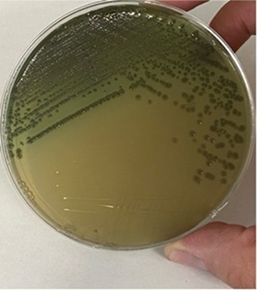
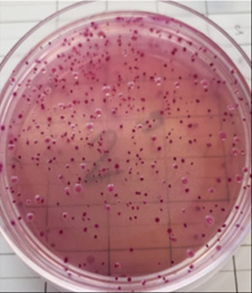

Introducción
La ganadería lechera representa una actividad primaria de gran relevancia en México, no solo por su impacto económico, sino también por su capacidad para generar productos con valor agregado1. Según el Servicio de Información Agroalimentaria y Pesquera (SIAP), la producción de leche de vaca aumentó un 2.3 % entre 2019 y 2020, alcanzando los 12,563 millones de litros, con una tasa media de crecimiento anual del 1.5 % desde 19801,2. Este crecimiento refleja una demanda sostenida de leche tanto para consumo directo como para su industrialización e importación2. A pesar de este incremento, persiste un déficit entre la producción nacional y la demanda interna, atribuido a factores como el limitado acceso a tecnología, falta de capacitación y desigualdad en el acceso a servicios gubernamentales3,4. Frente a esta situación, la producción artesanal de quesos continúa vigente en regiones como Aculco, Estado de México, donde se conservan prácticas tradicionales dentro de las llamadas cuencas queseras-lecheras5. Datos de la Encuesta Nacional de Ingresos y Gastos de los Hogares 2020 del INEGI muestran que el 28 % del gasto familiar se destina a alimentos y bebidas, y de este porcentaje, el 9 % corresponde al consumo de leche y derivados, incluyendo un promedio mensual de $289.00 en leche y $254.00 en otros lácteos como quesos6. Aunque una parte significativa del consumo proviene de productos industrializados, los quesos artesanales mantienen una presencia relevante en el mercado nacional6.
La creciente preferencia por productos tradicionales y de origen orgánico ha impulsado la compra de alimentos elaborados artesanalmente6. En este contexto, se reconocen dos tipos de queserías: la artesanal, que se caracteriza por su dependencia de la destreza manual y mínima tecnología; y la tradicional o familiar, donde se preservan recetas heredadas y características únicas reconocidas localmente5. Ambas fomentan la economía local y tienen un impacto positivo en el turismo regional6. A pesar del avance de la agroindustria, la demanda de quesos artesanales ha aumentado debido al valor simbólico que aportan: identidad cultural, historia familiar y características sensoriales únicas7. Estos factores se han convertido en herramientas de comercialización frente a los productos industrializados7.
En México, cerca del 75 % de la producción quesera corresponde a plantas de pequeña escala dedicadas a la elaboración artesanal, siendo los quesos blandos el principal destino de la leche, con una proporción del 75 a 80 % frente al 20-25 % destinada a quesos duros o semiduros8,9. Sin embargo, este tipo de producción también conlleva riesgos. La ausencia de procesos estandarizados puede comprometer la calidad e inocuidad de los productos, aumentando el riesgo de enfermedades transmitidas por alimentos10. Entre los principales retos que enfrentan los quesos mexicanos genuinos destacan la variabilidad en calidad y sanidad, altos costos de producción, problemas de comercialización, falta de cumplimiento normativo y un futuro incierto para muchos productores11.
Aunque existen esfuerzos para estandarizar la elaboración de quesos artesanales, las condiciones variables de cada unidad de producción dificultan su implementación. No obstante, mejorar la inocuidad es un objetivo prioritario para reducir riesgos sanitarios10.Todo productor tiene la responsabilidad de garantizar la calidad de sus alimentos. Para ello, debe considerar las Buenas Prácticas de Manufactura y cumplir con la normatividad vigente, especialmente con la NOM-210-SSA1-2014, que regula los métodos de prueba microbiológicos, y la NOM-113-SSA1-1994, que establece el método para la cuenta de coliformes totales12,13.
Material y métodos
El lugar de estudio fue el municipio de Aculco, Estado de México, México, reconocido por la producción y venta de quesos artesanales, ubicado a 2,400 m de altitud y caracterizado por tener una temperatura promedio de 14 ºC y clima subhúmedo característico de montaña. Se realizaron cuatro muestreos en distintas fechas: 25 de septiembre, 8 de noviembre, 8 de enero y 8 de marzo; se realizaron en tres queserías, codificadas de la siguiente forma:
Quesería A (QSA); Quesería B (QSB); Quesería C (QSC), en las cuales se producen quesos tipo manchego, ranchero, queso de hebra, botanero, panela y del morral. Con la finalidad de caracterizar el proceso artesanal de cada una de las queserías, se realizaron observaciones durante el proceso tomando en cuenta los siguientes rubros de las Buenas Prácticas de Manufactura (BPM): Las BPM relacionadas a las actividades del personal; las BPM relacionadas a las instalaciones; las BPM relacionadas al uso de herramientas y de utensilios antes, durante y después del proceso.
Para obtener un diagnóstico de situación de cada una de las queserías, y con el objetivo de analizar la información para concluir si la contaminación de los productos estaba relacionada con malas prácticas de manufactura, se aplicaron cuestionarios dicotómicos, cuya elaboración se basó en los puntos del Manual de BPM para la elaboración de los productos lácteos de la FAO9, así como los estudios realizados por otros autores10, para la caracterización de las queserías evaluadas. De la misma forma, se observó el proceso de elaboración para obtención de pruebas durante la elaboración de los distintos quesos para todas las queserías; también se participó en la elaboración de queso ranchero, queso de hebra y queso del morral en las tres queserías, para facilitar la aplicación del cuestionario con los queseros encargados y observar la rutina del proceso de manufactura y empaquetado.
Toma y envío de muestras
Las muestras de los quesos se obtuvieron con base en la referencia del PROYECTO NOM-109-SSA1-1994 “Proyecto de Norma Oficial Mexicana, Bienes y Servicios, Procedimientos para la Toma, Manejo y Transporte de Muestras de Alimentos para su Análisis Microbiológico”, para alimentos expuestos al aire libre y otros contaminantes, realizando el correcto lavado de manos, además de utilizar bata, cofia, cubrebocas y guantes estériles. Para almacenar las muestras, se utilizaron bolsas de polietileno estériles identificando claramente cada una de ellas, y se conservaron en hieleras de poliestireno con refrigerantes para conservarlas a una temperatura aproximada de 4 ºC hasta su traslado al laboratorio en un período no mayor a 12 h para su procesamiento microbiológico inmediato sin exceder 24 h de la recolección14.
Estimación de la cuenta de S. aureus
Se utilizó el Método de Referencia para la estimación de la cuenta de Staphylococcus aureus de acuerdo con el apéndice B normativo de la Norma Oficial Mexicana NOM-210-SSA1-2014, productos y servicios. Métodos de prueba microbiológicos. Determinación de microorganismos indicadores. Determinación de microorganismos patógenos12.
Para cada queso se transfirieron 25 g a frascos de dilución con 225 ml de solución reguladora de fosfatos estéril, para preparar una dilución 1:10, se transfirieron por medio de una pipeta estéril 0.1 ml de la suspensión inicial (dilución 10-1) por duplicado a cajas de agar Baird Parker y se repitió el procedimiento para las diluciones siguientes. Se distribuyó el inóculo sobre la superficie del agar con varillas estériles de vidrio en ángulo recto, utilizando una para cada placa y dilución. Se mantuvieron las placas con las tapas hacia arriba hasta que el inóculo se absorbió totalmente por el agar. Se invirtieron las placas y se incubaron por 48 h a 37 oC; transcurrido este tiempo se buscaron colonias con morfología colonial típica, es decir, colonias negras, circulares, brillantes, convexas, lisas, de diámetro de 1 a 2 mm y que mostraron una zona opaca, húmedas y con un halo claro (debido a la actividad de la lecitinasa) alrededor de la colonia. Se seleccionaron las placas que tuvieron entre 15 y 150 colonias típicas y atípicas de S. aureus; se seleccionaron por muestra cinco colonias típicas para su confirmación para la realización de la tinción de Gram; para confirmar la presencia de S. aureus, se realizaron las pruebas de coagulasa, catalasa y utilización anaeróbica de glucosa y manitol12.
Presencia de Salmonella spp.
Se utilizó el Método de referencia para el aislamiento de Salmonella spp. de acuerdo con el apéndice A normativo: Método de referencia para el aislamiento de Salmonella spp. de la Norma Oficial Mexicana NOM-210-SSA1-2014, Productos y servicios. Métodos de prueba microbiológicos. Determinación de microorganismos indicadores. Determinación de microorganismos patógenos12.
Se realizó una suspensión inicial con 25 g de cada muestra de queso en 225 ml de agua peptonada estéril como medio de pre-enriquecimiento para obtener una dilución 1:10 y se incubó la dilución inicial a 37 °C por 18 h. Para el enriquecimiento selectivo se transfirió 0.1 ml del cultivo de pre-enriquecimiento a un tubo de 10 ml de caldo Rappaport Vassiliadis Soya (RVS) y 1 ml a un tubo conteniendo 10 ml de caldo Muller Kauffmann Tetrationato-Novobiocina (MKTTn). Se incubó el caldo RVS a 41.5 °C por 24 h y el caldo MKTTn a 36 °C por 24 h. Para el aislamiento, se utilizó un juego de cajas de agar constituyendo una caja de agar xilosa-lisina-desoxicolato (XLD), una de verde brillante y una de sulfito bismuto. Con un asa bacteriológica, se sembraron las cajas de agar con la técnica de cultivo puro. Una vez terminado este proceso, se incubaron las cajas a 36 °C por 24 h; una vez transcurrido el tiempo de incubación, se revisó cada una de las cajas de agar en búsqueda de colonias sospechosas a Salmonella spp. Para confirmar la presencia de Salmonella spp. se tomó al menos una colonia sospechosa de los medios de cultivo para la inoculación en el agar nutritivo por medio de estría y se incubó a 36 °C por 24 h; una vez transcurrido este tiempo, se realizó la siembra de los agares lisina hierro (LIA) y triple azúcar hierro (TSI). Para el agar LIA se sembró por picadura a 1.5 cm del fondo del medio, en el agar TSI se sembró el medio por picadura en el fondo y estría en superficie inclinada; una vez realizada la inoculación, ambas pruebas se incubaron a 36 °C por 24 h, transcurrido el tiempo de incubación, se realizó la lectura de las pruebas bioquímicas12.
Estimación de coliformes totales en placa
Se utilizó el método para la cuenta de microorganismos coliformes totales en placa de acuerdo con la Norma Oficial Mexicana NOM-113-SSA1-1994, Bienes y servicios. Método para la cuenta de microorganismos coliformes totales en placa13.
Se inició preparando el medio de cultivo agar bilis y rojo violeta de acuerdo con las instrucciones del fabricante; una vez homogeneizado el medio, se esterilizó con autoclave. Terminando este proceso se retiró el medio de cultivo y se mantuvo a temperatura de 45 °C hasta su uso dentro del procedimiento. Se preparó una dilución primaria de 10 g de muestra y se agregaron a 90 ml de diluyente (agua peptonada estéril), después se metió la dilución en la licuadora por 2.5 min hasta tener una mezcla homogénea; posterior a esto, se transfirió 1 ml de la dilución inicial al primer tubo de ensayo, homogeneizando y transfiriendo un mililitro al siguiente tubo hasta tener cinco diluciones. Se utilizó una caja de Petri por duplicado para cada una de las muestras, a cada caja de Petri se añadió un mililitro para cada una de las diluciones y se le agregaron 13 ml del medio de cultivo; inmediatamente se realizó la mezcla del inóculo con el medio con seis movimientos de derecha a izquierda y seis movimientos en sentido de las manecillas del reloj y seis movimientos al contrario, todo sobre una superficie plana13. Una vez solidificado el medio, se invirtieron las placas y se incubaron a 35 °C durante 24 h; transcurrido este tiempo, se retiraron las cajas de la incubadora para su observación, seleccionando las placas que tuvieron entre 15 y 150 colonias típicas, las cuales son de color rojo con halo de precipitación debido a las sales biliares de color rojo claro o rosa, con morfología colonial de lentes biconvexos con un diámetro de 0.5 a 2 mm13.
Análisis de datos
Se realizó la operacionalización de las muestras por tipo de queso y por quesería. Se utilizaron las pruebas de normalidad Kolmogorov-Smirnov y Shapiro-Wilk para determinar si los datos seguían una tendencia normal. Se utilizó la prueba de Kruskal-Wallis para comparar una distribución entre distintos grupos, en este caso, los tipos de queso. Para la aplicación de las pruebas estadísticas, se utilizó programa Excel y SPSS versión 29.0. Se otorgaron puntajes a las respuestas de los cuestionarios y a lo observado durante el proceso de elaboración para cuantificar el cumplimiento de las BPM de la siguiente manera:
Puntaje de 0, no se cumple el requerimiento. Puntaje de 1, se cumple parcialmente. Puntaje de 2, se cumple el requerimiento.
Para caracterizar las queserías se utilizó el modelo de García-Rincón15 (%Cumplimiento BPM= Puntaje obtenido (POB)/Puntaje máximo (PMX)*100), colocándolas en tres posibles categorías dependiendo de su porcentaje de cumplimiento:
Favorable: puntaje de 90-100 %; favorable con requerimientos: puntaje de 60-89 %; Desfavorable: puntaje menor a 59 %.
Resultados
Se obtuvieron 36 muestras de quesos de los productores distribuidos de la siguiente manera:
Quesería A (QSA), donde se muestrearon: 5 quesos de hebra, 4 quesos rancheros, 1 queso tipo manchego.
Quesería B (QSB), donde se muestrearon: 4 quesos rancheros, 4 quesos de hebra, 3 quesos del morral, 1 queso panela, 1 queso tipo manchego.
Quesería C (QSC), donde se muestrearon: 4 quesos rancheros, 4 quesos botaneros, 4 quesos tipo manchego, 1 queso de hebra.
Se realizaron observaciones y se llenaron los cuestionarios durante la estancia en las queserías, pudiendo observar todo el proceso para las variedades de quesos muestreados, desde la recepción de la leche hasta el empaquetado y almacenamiento de los productos. Se expresaron los resultados obtenidos de las observaciones y cuestionarios realizados (Cuadros 1 y 2). Se determinó el total del puntaje obtenido en los cuestionarios y su porcentaje de cumplimiento de BPM caracterizándolas de la siguiente manera:
QSA: favorable con requerimientos (79.3 %); QSB: desfavorable (45.7 %); QSC: desfavorable (13 %).
Cuadro 1 Calificación obtenida en cada una de las queserías de acuerdo a las BPM que se evaluaron
| Queserías | |||
|---|---|---|---|
| BPM relacionadas a las actividades del personal | QSC | QSB | QSA |
| Higiene personal | 0 | 1 | 2 |
| Uso correcto del uniforme | 1 | 1 | 0 |
| Lavado de manos | 0 | 1 | 1 |
| Sin joyería | 0 | 2 | 2 |
| Uso correcto de cofia y cubrebocas | 0 | 0 | 0 |
| Sin evidencias de comer, masticar chicles, tomar bebidas o fumar durante el proceso | 0 | 0 | 2 |
| Objetos personales en lugares definidos para este fin | 0 | 1 | 2 |
| Capacitación en BPM | 0 | 0 | 0 |
| Control de registro e higiene de personal | 0 | 0 | 0 |
| BPM relacionadas a las instalaciones | QSC | QSB | QSA |
| Uso de las instalaciones exclusivas para la elaboración de los quesos | 0 | 2 | 2 |
| El área del proceso está apartada de otras áreas que pudieran causar contaminación cruzada | 0 | 0 | 2 |
| El diseño de la quesería permite la limpieza correcta de la misma (pisos, paredes y techos) | 0 | 1 | 2 |
| Ventilación adecuada | 0 | 1 | 2 |
| Libre de plagas | 0 | 0 | 0 |
| Iluminación adecuada | 1 | 2 | 2 |
| Almacenamiento correcto de las materias primas | 0 | 2 | 2 |
| Almacenamiento correcto del producto terminado | 2 | 1 | 2 |
| Almacenamiento correcto de químicos | 1 | 2 | 2 |
| El exterior del establecimiento está en buenas condiciones de mantenimiento y limpieza | 0 | 0 | 2 |
| BPM relacionadas a utensilios durante el proceso | QSC | QSB | QSA |
| Diseño de equipos y utensilios que permiten su fácil limpieza y desinfección | 1 | 2 | 2 |
| Se tiene establecido una rutina de limpieza y desinfección de utensilios | 0 | 2 | 2 |
| Existe una rutina de limpieza previo a la elaboración del proceso | 0 | 0 | 1 |
| Áreas libres de utensilios y equipo en desuso | 0 | 0 | 2 |
Cuadro 2 Observaciones del proceso de producción
| Quesería A | Quesería B | Quesería C | |
|---|---|---|---|
| Historia y estructura familiar |
Fundada por el padre de la dueña actual. Trabajan familiares y cinco personas externas. | Trabajan familiares (abuelo y nietas), así como dos queseros externos a la familia. | Trabajan dos padres, hijas y nietos, así como dos trabajadores externos. |
| Rutina de limpieza |
Lavado de recipientes con agua y jabón, sin embargo, es insuficiente al encontrar restos de cuajada de días anteriores en el molino de la quesería. | Lavado de recipientes desgastados y mesas con agua y jabón. | Lavado superficial de mesas de trabajo con agua sin jabón ni detergente. Lavado de cubetas con agua y suero resultante del proceso de manufactura. Lavado de recipientes con agua y jabón en polvo. |
| Quesería y BMP |
Uso de botas de trabajo y mandil, no aceptan el uso de cofia y cubrebocas; no utilizan el lavabo para lavarse las manos. Puertas abiertas de la quesería al momento de realizar los quesos, por lo tanto, hay corrientes de aire y moscas sobre la cuajada. | Uso de botas, mandil y cofia, pero no cubrebocas. Cortinas tipo hawaianas en la entrada de la quesería, ausencia de lavado de manos la cual la realizan en una cubeta. Refrigerador de almacenamiento con puerta averiada. | Puerta abierta de la quesería y cristales rotos que permiten la entrada de moscas. No cuentan con ropa de trabajo, ni uso de cofia, mandil, cubrebocas y botas de trabajo. Cubetas contaminadas con heces de bovino. Carecen de área de lavado de manos, solo las enjuagan con el suero de la leche. |
Conteo, aislamiento e identificación de S. aureus
En las pruebas para la determinación de UFC/g de queso para S. aureus se observaron colonias típicas en el agar Baird-Parker, redondas de bordes lisos, convexas, de 1-2 mm de diámetro, húmedas, brillantes y negras con la formación del halo claro alrededor de la colonia debido a la acción de la lecitinasa (Figura 1). Al realizar las pruebas confirmatorias para presencia de S. aureus se observaron resultados positivos para la prueba de coagulasa, determinados por la formación del coágulo a las 24 h; de la misma forma se observó una reacción positiva a la prueba de catalasa y se observaron cocos grampositivos agrupados en racimos con la tinción de Gram de las colonias sospechosas. Al realizar el conteo (Cuadro 3) se determina que la mayoría de los quesos muestreados no cumple con los límites permitidos por la NOM-210-SSA1-201412.
Colonias de 1-2 mm de diámetro, húmedas, brillantes y negras con la formación del halo claro alrededor de la colonia debido a la acción de la lecitinasa
Figura 1 Colonias de Staphylococcus aureus en agar Baird-Parker
Cuadro 3 Conteo de S. aureus en los 36 quesos muestreados
| Nombre de la quesería | Tipo de queso | UFC/g 25 sept |
UFC/g 08 nov |
UFC/g 08 enero |
UFC/g 07 marzo |
|---|---|---|---|---|---|
| QSA | Queso de hebra | 54 | 10,000 | 4000 | 150,000 |
| QSA | Ranchero | 150,000 | 10,000 | 280,000 | 150,000 |
| QSA | Queso de hebra madurado y ahumado | NA | 10,000 | NA | NA |
| QSA | Queso manchego | NA | NA | NA | 150,000 |
| QSB | Ranchero | 162 | 10,000 | 220,000 | 150,000 |
| QSB | Queso del morral | 173 | 10,000 | NA | 150,000 |
| QSB | Queso de hebra | 150,000 | 10,000 | 100,0000 | 150,000 |
| QSB | Queso panela | NA | NA | 1,100,000 | NA |
| QSB | Queso manchego | NA | NA | 300,000 | NA |
| QSC | Ranchero | 150,000 | 10,000 | 3’900,000 | 150,000 |
| QSC | Queso de hebra | 150,000 | NA | NA | NA |
| QSC | Botanero | 150,000 | 10,000 | 9’400,000 | 150,000 |
| QSC | Manchego | 150,000 | 10,000 | 8’500,000 | NA |
| QSC | Manchego habanero | NA | NA | NA | 150,000 |
NA= no aplica. No se observaron diferencias estadísticamente significativas entre las distintas fechas de muestreo (P>0.05).
Al realizar la estadística descriptiva, se trabajó con mediana, PE25 y PE75 como medida de tendencia central y medidas de dispersión. Se aplicó la prueba de Kruskal-Wallis para comparar la distribución de unidades formadoras de colonia (UFC) de S. aureus con respecto a los distintos tipos de queso en los diferentes días de muestreo, dando como resultado la conservación de la hipótesis nula para cada uno de los casos, es decir, todos los tipos de queso tienen la misma distribución de UFC en los distintos días de muestreo.
Determinación de presencia o ausencia de Salmonella spp
En las pruebas para la determinación de presencia de Salmonella spp no se observaron colonias en los medios selectivos de agar XLD ni en agar verde brillante; sin embargo, se encontraron 25 muestras con colonias sospechosas en el agar sulfito bismuto (Figura 2). Al realizar las pruebas confirmatorias para las colonias sospechosas, no se observó cambio de coloración en los medios TSI y LIA, que pudieran indicar la presencia de Salmonella spp. Por lo que se determinó la ausencia de Salmonella spp en todos los quesos muestreados para todas las unidades de producción (Cuadro 4) y que cumplen con el requisito marcado en la NOM-210-SSA1-2014, Productos y servicios.
Cuadro 4 Presencia/ausencia de Salmonella spp en los 36 quesos muestreados
| Nombre de quesería |
Tipo de queso | UFC/g 25 sept |
UFC/g 08 nov |
UFC/g 08 enero |
UFC/g 7 marzo |
|---|---|---|---|---|---|
| QSA | Queso de hebra | Ausente | Ausente | Ausente | Ausente |
| QSA | Ranchero | Ausente | Ausente | Ausente | Ausente |
| QSA | Queso de hebra madurado y ahumado | NA | Ausente | NA | NA |
| QSA | Queso manchego | NA | NA | NA | Ausente |
| QSB | Ranchero | Ausente | Ausente | Ausente | Ausente |
| QSB | Queso del morral | Ausente | Ausente | NA | Ausente |
| QSB | Queso de hebra | Ausente | Ausente | Ausente | Ausente |
| QSB | Queso panela | NA | NA | Ausente | NA |
| QSB | Queso manchego | NA | NA | Ausente | NA |
| QSC | Ranchero | Ausente | Ausente | Ausente | Ausente |
| QSC | Queso de hebra | Ausente | NA | NA | NA |
| QSC | Botanero | Ausente | Ausente | Ausente | Ausente |
| QSC | Manchego | Ausente | Ausente | Ausente | NA |
| QSC | Manchego habanero | NA | NA | NA | Ausente |
NA= no aplica. No se observaron diferencias estadísticamente significativas entre las distintas fechas de los muestreos (P>0.05).
Determinación de coliformes totales en placa
Se detectaron colonias típicas de color rojo con halo de precipitación con las características típicas de coliformes en el agar bilis y rojo violeta (Figura 3) y al realizar el conteo (Cuadro 5) se determinó que la mayoría de los quesos muestreados no cumple con los límites permitidos por la NOM-113-SSA1-1994, la cual establece que el límite máximo de organismos coliformes totales es de <100 UFC/g13. Al realizar la estadística descriptiva, se trabajó con mediana, PE25 y PE75 como medida de tendencia central y medidas de dispersión. Se aplicó la prueba de Kruskal-Wallis para comparar la distribución de coliformes totales con respecto a los distintos tipos de queso en los diferentes días de muestreo, obteniendo como resultado que todos los tipos de queso tienen la misma distribución de UFC en los distintos días de muestreo. Se realizó la prueba de Friedman para las pruebas que tuvieron un registro completo, y se estableció que las distribuciones del 25 de septiembre, 8 de noviembre, 8 de enero y 7 de marzo obtuvieron una significancia donde (P<0.05), es decir, sí existió una diferencia estadística. Al existir una diferencia estadística, resultado de la prueba de Friedman, se realizó una comparación por parejas con una significancia ajustada entre las distintas fechas de los muestreos, dando como resultado que la cuantificación de UFC para coliformes del muestreo del 8 de noviembre es mayor que el que se realizó el 25 de septiembre.
Cuadro 5 Conteo de coliformes totales en placa en los 36 quesos muestreados
| Nombre de quesería |
Tipo de queso | UFC/g 25 sept* |
UFC/g 08 nov* |
UFC/g 08 enero* |
UFC/g 07 marzo* |
|---|---|---|---|---|---|
| QSA | Queso de hebra | 700,000 | 5’900,000 | 12,000 | 1,000 |
| QSA | Ranchero | 250 | 15’000,000 | 10,000 | 8’000,000 |
| QSA | Queso de hebra madurado y ahumado |
NA | 60 | NA | NA |
| QSA | Queso manchego | NA | NA | NA | 15’000,000 |
| QSB | Ranchero | Ausente | 200,000 | Ausente | 15’000,000 |
| QSB | Queso del morral | 160 | 200,000 | NA | 7’300,000 |
| QSB | Queso de hebra | Ausente | 1’100,000 | 8’500,000 | 15’000,000 |
| QSB | Queso panela | NA | NA | 70,000 | NA |
| QSB | Queso manchego | NA | NA | 700,000 | NA |
| QSC | Ranchero | 43 | 15’000,000 | 100,000 | 3’500,000 |
| QSC | Queso de hebra | 20 | NA | NA | NA |
| QSC | Botanero | 45,000 | 15’000,000 | 6’600,000 | 1’900,000 |
| QSC | Manchego | 300 | 15’000,000 | 11’200,000 | NA |
| QSC | Manchego habanero |
NA | NA | NA | 12’000,000 |
NA= no aplica. Las fechas marcadas con asterisco indican diferencias significativas (P<0.05) entre los muestreos
Discusión
De acuerdo con los resultados de los análisis microbiológicos, se puede establecer que los quesos elaborados de manera artesanal de las unidades de producción que se muestrearon en el municipio de Aculco, Estado de México, México, superan los límites permitidos por la normatividad respecto a S. aureus y coliformes totales; sin embargo, Salmonella spp se encuentra ausente en todas las muestras procesadas. La ausencia de Salmonella spp en los resultados obtenidos pueden indicarnos una contaminación limitada o una carga muy baja de la bacteria en los productos evaluados en las tres queserías; sin embargo, estos resultados difieren de los reportados en otros trabajos de investigación15,16 en donde que se obtuvieron resultados positivos a la presencia de Salmonella spp. del 50 % y 33 % respectivamente del total de queserías muestreadas cuyas condiciones no eran favorables respecto a la inocuidad de los procesos de manufactura, similares a las del presente trabajo. Debido a esto, no se puede descartar totalmente la presencia de Salmonella spp. en los quesos muestreados, por lo que se recomendaría hacer pruebas moleculares y métodos inmunoenzimáticos para confirmar los resultados16,17,18.
Los resultados de los análisis microbiológicos para S. aureus demuestran que la mayoría de los quesos presentan límites mayores a los permitidos por la NOM (1,000 UFC/g); sólo tres quesos de los 36 entran en los límites establecidos, es decir 8.33 %. El promedio más alto registrado fue en la Quesería C, con un valor de 1’749,615 UFC/g, mientras que la Quesería A presenta el valor promedio más bajo 91,405 UFC/g. De acuerdo con el análisis estadístico, se determinó que existe la misma distribución en la cuantificación de las UFC para S. aureus y coliformes totales independientemente del tipo de queso que se procesó, por lo que se pueden asociar los altos conteos bacteriológicos directamente al proceso de manufactura, considerando que las queserías se caracterizaron por tener un porcentaje de cumplimiento de BPM desfavorables o favorables con requerimientos.
Dentro de los hallazgos de este análisis estadístico, se determinó que en el caso de las coliformes totales, sí existió una diferencia estadística en los resultados del muestro de septiembre en contraste con el muestreo de noviembre, siendo menor la cuantificación de las UFC en el muestreo de septiembre. Esto puede deberse a que se les notificó a los productores que se realizarían análisis de los productos y una posible revisión del proceso de manufactura, por lo que se reportaron prácticas distintas a las cotidianas dentro de las queserías implementando una mejora en las BPM para el primero de los muestreos, mientras que los demás se hicieron sin un aviso previo del día en que se muestrearían los productos. Algunos de esos cambios fueron: uso adecuado del cubrebocas, sanitización de utensilios y mesas de trabajo con agua limpia y jabón y un lavado de manos más constante.
Los resultados del análisis microbiológico para coliformes totales en placa demuestran que la mayoría de los quesos (88.89 %) presenta UFC/g mayores a los límites permitidos por la NOM-113-SSA1-1994. Sólo cuatro quesos están por debajo de los límites establecidos, es decir 11.11 %. El dato más alto registrado fue en la Quesería C, obteniendo un promedio de 6’180,412 UFC/g en promedio de los productos muestreados, mientras que la Quesería B tuvo el menor promedio de UFC/g de queso con 3’697,704. A pesar de que la quesería B se categoriza con una condición de desfavorable, la aplicación de prácticas para controlar corrientes de viento y un mayor control de moscas por medio del uso de mosquiteros y hawaianas en el ingreso de la quesería, implican un mayor control en la contaminación por coliformes, a diferencia de las otras dos queserías. En el caso de la Quesería A, se obtuvieron los conteos más bajos en carga de UFC por S. aureus, esto puede deberse a que en su quesería se tiene más control en el proceso de manufactura y de las actividades de los trabajadores, dándoles cubrebocas antes de ingresar al proceso, destinando un área para el lavado de manos, vigilando la higiene de los trabajadores al ingreso del proceso y evitando el uso de artículos de uso personal como pulseras, relojes o anillos. No obstante, algunas de estas prácticas se cumplían parcialmente durante el proceso y de acuerdo a otros autores10, factores mínimos como el uso inadecuado del cubrebocas, la apertura continua de las puertas para la recepción de la leche, así como la falta de participación por parte de los trabajadores para el uso del lavamanos y el lavado de manos inadecuado terminan en un producto que, a pesar de no ser el más alto en conteos de coliformes totales en placa y ser el más bajo en el conteo de UFC para S. aureus, sigue sin cumplir los límites establecidos por la normatividad.
Dentro del proceso, es importante considerar la conservación del producto después del empaquetado, los productos no se mantenían en refrigeración más de dos días antes de ofrecerlos al público o llevarlos al punto de venta para el caso de todas las queserías, sin embargo, en el punto de venta de la Quesería B se encontraron quesos que llevaban en refrigeración más de 5 días. A pesar de contar con BPM con las que las otras dos queserías no contaban, se observó que el refrigerador donde se conservaban los productos para venta no cerraba de manera correcta; de acuerdo a Aguirre-Alcántara19 la vida útil de los alimentos dependerá de la formulación o elementos que conforman al producto, el procesamiento adecuado, el empaquetado y las condiciones posteriores al mismo, entre ellos su conservación; en su estudio se determinó que cuando los productos se mantienen a temperatura ambiente o en refrigeración teniendo altas cargas bacterianas (mayor a 1,100 UFC/g de queso para coliformes totales y mayor a 5,000 UFC/g para S. aureus), se produce un cambio en las características organolépticas, dándonos como resultado un producto con vida útil no mayor a cuatro días por el riesgo sanitario. Sin embargo, no se descartan los puntos de la presencia de vectores durante el proceso de elaboración, las corrientes de viento por ventanas abiertas y la falta de sanitización de algunas herramientas para la elaboración del queso, tal y como lo mencionan otras investigaciones10.
En contraste con la Quesería C, en la que se observaron los conteos más altos por UFC para S. aureus y para coliformes totales en placa, si se comparan los promedios obtenidos con respecto a los resultados del diagnóstico de situación de las queserías, se puede concluir que al ser una unidad de producción que recién inicia la elaboración de quesos artesanales, no ha tenido una mejora en cuanto a la estandarización de su proceso de manufactura ni en la elaboración de un protocolo de limpieza, conservación del producto y de inocuidad durante el procesamiento; así como factores de riesgo como el hecho de que la quesería comparte área con ganado bovino, aves y perros de la zona, aunado a que las instalaciones con las que se cuentan para llevar a cabo la actividad son inadecuadas debido al tipo de piso, problemas de aumento de temperatura que obligan a las queseras a trabajar con la puerta abierta y que la única zona que permitiría un lavado de manos adecuado se encuentra fuera de la quesería. A diferencia de las Queserías A y B, los productos de la Quesería C no tienen el mismo alcance debido a la capacidad productiva en cuanto a instalaciones y mano de obra disponible para el trabajo, limitándose a la elaboración de pocas piezas y a la venta en las inmediaciones de la Ciudad de México. De acuerdo con otros autores19 las características físico-químicas y microbiológicas de los productos facilitan su comercialización en distintos nichos del mercado, al ofrecer un producto de mayor calidad y mayor vida de anaquel, por lo que un proceso más estandarizado, buenas prácticas de higiene por parte de los trabajadores y reducción del flujo constante de trabajadores fuera y dentro de la quesería, podría traducirse en una mejora significativa en la calidad e inocuidad de los productos, evitando de manera inicial una inversión considerables en la tecnificación de su proceso.
Los resultados obtenidos son similares a los obtenidos en otros estudios20, en los cuales se determinó que un 97.4 % de los quesos muestreados para su estudio se encontraban fuera de los valores normales, con ausencia de Salmonella spp, coincidiendo con lo reportado por otros trabajos21, bajo condiciones similares para la elaboración de quesos frescos. Ambos casos comparten la tendencia de las queserías artesanales en las que existe contaminación por la ausencia de las medidas sanitarias o mala implementación de las mismas. A pesar de no poseer la infraestructura necesaria para realizar un proceso más tecnificado, en todos los casos se cuentan con ciertos elementos y herramientas que poseen las características adecuadas para la elaboración del queso; sin embargo, independientemente del grado de tecnificación con la que cuenta cada quesería, en todos los procesos se observó la contaminación de ciertas herramientas de trabajo e insumos antes del inicio del mismo, y la sanitización adecuada de los utensilios y mesas de trabajo al final de este. De acuerdo con algunos autores21, los conteos altos en los resultados microbiológicos pueden derivarse de una contaminación cruzada con los utensilios y herramientas utilizadas durante el proceso de manufactura, existiendo relación entre lo obtenido en los resultados del diagnóstico de situación de las queserías y los conteos bacteriológicos. Autores reportan resultados similares en cuanto a los niveles de contaminación por S. aureus y coliformes en queserías que comparten condiciones de instalaciones y procesos similares, sin embargo, mencionan que los productores demuestran interés y apertura para la implementación de técnicas que mejoren la calidad de sus productos, algo similar a lo observado durante la evaluación de las queserías22.
Las productoras y productores mostraron interés genuino en las observaciones que se realizaron durante la evaluación de su proceso, principalmente en el caso de la Quesería de A, misma que resultó con el menor promedio en los conteos bacteriológicos y a la que se asoció una presencia más marcada en la implementación de BPM. Continuando con lo reportado por otros autores10,22, se pueden sugerir cambios básicos durante la manufactura, como el recorte adecuado de uñas, tener ropa de trabajo exclusiva para la quesería, la limpieza y desinfección de las áreas, así como mantener siempre limpio el material que se utilizará para la elaboración y evitar su uso en otras áreas de trabajo para que, una vez estandarizadas los programas generales de limpieza, BPM, POES y control de proveedores, se pueda proceder a la realización de un HACCP para mejorar las características del producto e incluso poder llegar a una certificación. Las unidades de producción donde se realizó el estudio son enteramente artesanales y familiares, con procesos que han seguido a lo largo de los años para el caso de la Quesería A y B, sin embargo, en el caso de la Quesería C se tiene una gran oportunidad de mejora y adquisición de nuevas prácticas de higiene que lleven a la elaboración de productos de mayor calidad y más redituables económicamente. De la misma forma, en el caso de las tres unidades de producción existe la participación de la siguiente generación familiar, con la disposición de aprender y poner en práctica actividades y procesos para otros productos lácteos para los que se han elaborado talleres por parte del proyecto; por lo que podría ser una oportunidad de enseñanza para implementar mejores prácticas de manufactura dentro de las queserías y modificar la calidad del producto para beneficio de los productores y prevención de riesgo para los consumidores.
Conclusiones e implicaciones
Ninguna de las unidades de producción evaluadas cumple con los estándares microbiológicos establecidos por la NOM para S. aureus ni coliformes totales, lo que evidencia que la ausencia de BPM durante la elaboración de quesos compromete su calidad e implica un riesgo sanitario para el consumidor, considerando las dosis infectivas mínimas de S. aureus (100,000 UFC/g) y E. coli (100-1000 UFC/g). El diagnóstico de situación y los resultados microbiológicos muestran una relación directa entre la falta de BPM y los altos niveles de contaminación, aunque se observó que su implementación, incluso sin mejoras en infraestructura, puede incrementar la inocuidad del producto, como lo sugiere la diferencia significativa entre los días de muestreo notificados y no notificados. Si bien las limitaciones económicas dificultan mejoras inmediatas en las instalaciones, se pueden promover acciones de sensibilización para reducir fuentes de contaminación, y el interés manifestado por las nuevas generaciones de productores ofrece una oportunidad para introducir cambios progresivos en las prácticas de producción hacia una mejora sostenible.